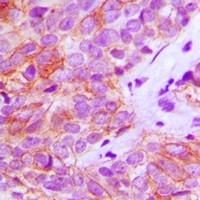

| 价格 | ¥1781.00 |
| 发货 | 湖北武汉市 |
| 运费 | 包邮:2000.00 |
| 规格 |
|
| 数量 | -+ |
| 库存 | 10件起订1件 |
| Catalog Number | orb213929 |
|---|---|
| Category | Antibodies |
| Description | Rabbit polyclonal antibody to FGFR3 |
| Species/Host | Rabbit |
| Clonality | Polyclonal |
| Tested applications | IF, IH, WB |
| Reactivity | Human, Mouse, Porcine, Rat |
| Immunogen | KLH-conjugated synthetic peptide encompassing a sequence within the center region of human FGFR3. The exact sequence is proprietary. |
| Dilution range | WB: 1-500-1-1000, IHC-P: 1-100-1-200 |
| Form/Appearance | Liquid in 0.42% Potassium phosphate, 0.87% Sodium chloride, pH 7.3, 30% glycerol, and 0.01% sodium azide. |
| Conjugation | Unconjugated |
| Target | FGFR3 |
| Entrez | 2261 |
| UniProt ID | P22607, Q61851 |
| Source | Rabbit |
| Storage | Maintain refrigerated at 2-8°C for up to 2 weeks. For long term storage store at -20°C in small aliquots to prevent freeze-thaw cycles. |
| Buffer/Preservatives | Liquid in 0.42% Potassium phosphate, 0.87% Sodium chloride, pH 7.3, 30% glycerol, and 0.01% sodium azide. |
| Alternative names | anti JTK4 antibody, anti Fibroblast growth factor Read more... |
| Note | For research use only |
| Expiration Date | 12 months from date of receipt. |